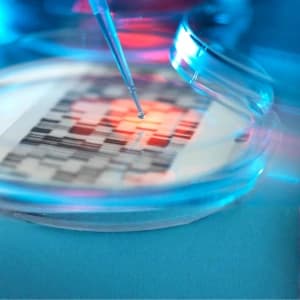
imagem

PÓS-GRADUAÇÃO - EAD

e atue com excelência no cuidado às vítimas de violência e na cooperação com a justiça

Graduados em Enfermagem que desejam atuar com excelência no atendimento a vítimas de violência e na interface com a justiça, e buscam:
Aguardamos a definição do(a) coordenador(a) responsável por este curso.

A Enfermagem Forense é uma área que presta serviços de cuidados de saúde as vítimas de violência, bem como, oferece suporte técnico na preservação de provas para investigação de crimes e coletas de materiais biológicos das vítimas e perpetradores. Colabora com a justiça realizando testemunho pericial na investigação de crimes e disponibiliza consultoria enfermagem, caso haja necessidade na apuração de fatores relacionados a saúde. Oferece ainda, serviços de planejamento e estratégias de reintegração de agressores e/ou pacientes psiquiátricos às famílias, para que estes tenham um convívio seguro.
Os estudos na área da enfermagem forense, partiram da necessidade de profissionais enfermeiros, capacitados para atendimento as vítimas de violência, visto que, a equipe de enfermagem, na maioria das vezes, tem o primeiro contato com o paciente que sofreu violência. Destaca-se ainda, que, além dos cuidados imediatos prestados as vítimas, o trabalho do enfermeiro forense é de extrema importância na detecção precoce e prevenção de violências, em especial em vítimas vulneráveis, como crianças e idosos.
A enfermagem forense no Brasil tem grande relevância, pois devido ao alto índice de violência presente no país, necessita-se de profissionais, com boa formação e preparados para o atendimento à população.
Objetivos do Curso
Especializar os profissionais de enfermagem no atendimento e prestação de cuidados às vítimas de violência de todo tipo de natureza: física, sexual, moral, psicológica, entre outras. Ainda, realizar investigação e coleta de materiais biológicos das vítimas e agressores, bem como, oferecer testemunho pericial e consultoria de enfermagem sobre cuidados de saúde em cooperação com a área jurídica, nos processos que necessitem do conhecimento em enfermagem forense.
A quem se destina: Profissionais graduados em enfermagem
A Enfermagem Forense é uma área que presta serviços de cuidados de saúde as vítimas de violência, bem como, oferece suporte técnico na preservação de provas para investigação de crimes e coletas de materiais biológicos das vítimas e perpetradores. Colabora com a justiça realizando testemunho pericial na investigação de crimes e disponibiliza consultoria enfermagem, caso haja necessidade na apuração de fatores relacionados a saúde. Oferece ainda, serviços de planejamento e estratégias de reintegração de agressores e/ou pacientes psiquiátricos às famílias, para que estes tenham um convívio seguro.
Os estudos na área da enfermagem forense, partiram da necessidade de profissionais enfermeiros, capacitados para atendimento as vítimas de violência, visto que, a equipe de enfermagem, na maioria das vezes, tem o primeiro contato com o paciente que sofreu violência. Destaca-se ainda, que, além dos cuidados imediatos prestados as vítimas, o trabalho do enfermeiro forense é de extrema importância na detecção precoce e prevenção de violências, em especial em vítimas vulneráveis, como crianças e idosos.
A enfermagem forense no Brasil tem grande relevância, pois devido ao alto índice de violência presente no país, necessita-se de profissionais, com boa formação e preparados para o atendimento à população.
Objetivos do Curso
Especializar os profissionais de enfermagem no atendimento e prestação de cuidados às vítimas de violência de todo tipo de natureza: física, sexual, moral, psicológica, entre outras. Ainda, realizar investigação e coleta de materiais biológicos das vítimas e agressores, bem como, oferecer testemunho pericial e consultoria de enfermagem sobre cuidados de saúde em cooperação com a área jurídica, nos processos que necessitem do conhecimento em enfermagem forense.
A quem se destina: Profissionais graduados em enfermagem
Nossa equipe é formada por especialistas renomados com ampla experiência acadêmica e prática. Eles estão aqui para orientar, inspirar e transformar sua trajetória profissional.
Na USCS, você encontra um ambiente acadêmico preparado para transformar conhecimento em prática. Nossa proposta é oferecer uma formação de qualidade, com professores experientes, infraestrutura moderna e metodologias que acompanham as demandas do mercado.
Aqui, o estudante é incentivado a desenvolver senso crítico, ampliar suas habilidades e construir uma trajetória sólida, tanto profissional quanto pessoal. Valorizamos a inovação, a pesquisa e a troca de experiências, criando oportunidades para que cada aluno possa explorar seu potencial ao máximo.
Estudar na USCS é investir em aprendizado contínuo, crescimento e novas possibilidades para o futuro.
Se preferir, entre em contato diretamente com nosso time de vendas pelo número (11) 2714-5699 ou clicando no ícone de WhatsApp a seguir:
CONTATO NO WHATSAPPTrabalhamos ao lado de grandes instituições e marcas que compartilham do mesmo propósito: oferecer qualidade, inovação e oportunidades para transformar vidas.